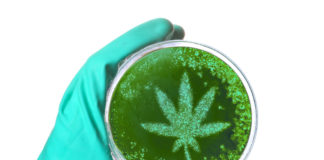
Largest Report on Cannabis Use Confirms Medical Benefits and Highlights Some Concerns shutterstock 553718719

© 2025 Incunabulum LLC. All rights reserved. mg Magazine is a registered trademark of Incunabulum LLC. The material on this site may not be reproduced, distributed, transmitted, cached or otherwise used, except with the prior written permission of Incunabulum LLC.